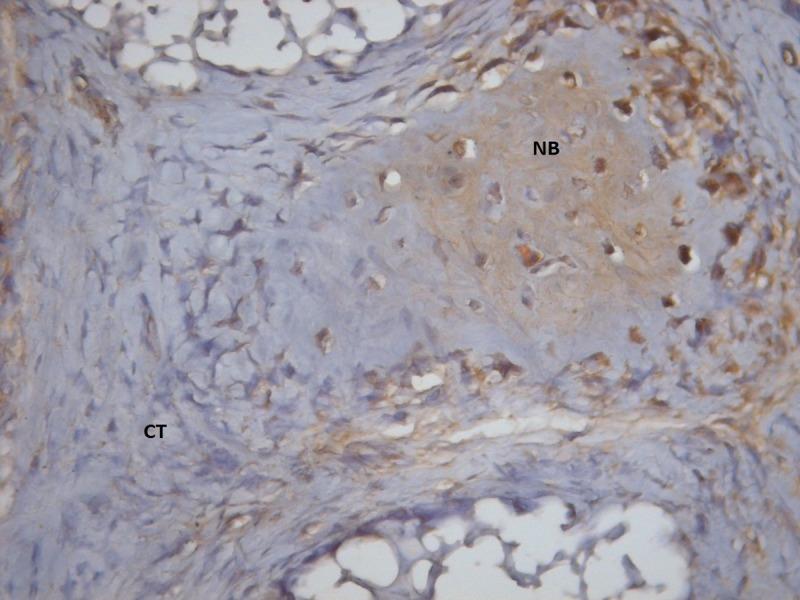
https://cdn.ncbi.nlm.nih.gov/pmc/blobs/f036/5573525/fc475cd4fca2/jiufd-050-001-b-e006.jpg

兔重复应用富血小板血浆后骨钙素和骨连接蛋白的表达
Osteocalcin and osteonectin expression after double application of platelet-rich plasma in rabbits.
作者信息
Ozdemir Burcu, Kurtis Bulent, Tuter Gulay, Senguven Burcu, Yildirim Benay
机构信息
Department of Periodontology, Faculty of Dentistry, Gazi University, Turkey.
出版信息
J Istanb Univ Fac Dent. 2016 Apr 1;50(2):1-9. doi: 10.17096/jiufd.40536. eCollection 2016.
PURPOSE
Platelet-rich plasma (PRP) is a novel method for transferring autogenous growth factors to the wound area. The aim of this study was to evaluate the efficacy of double-application of PRP (DA-PRP) on bone healing in rabbit cranial defects by examining osteonectin (ON) and osteocalcin (OC) expression.
MATERIALS AND METHODS
Twenty-eight rabbits, each with two surgically prepared calvarial bone defects, were included in this study and divided into six groups: The defects (N=56) were treated with either a single-application of PRP (SA-PRP) (n=10), a combination of SA-PRP and betatricalciumphosphate (SA-PRP+β-TCP) (n=10), only DAPRP (n=8), both DA-PRP and beta-tricalciumphosphate (DA-PRP+β-TCP) (n=8), only beta-tricalciumphosphate (β-TCP) (n=10), or controls (n=10). The animals were sacrificed at 30th day postoperatively and samples were immunohistochemically examined for ON and OC expressions.
RESULTS
It was determined that DA-PRP did not significantly improve the ON and OC percentages achieved by SA-PRP or the controls. The three groups treated with β-TCP showed a higher percentage of ON than those treated without β-TCP (p<0.05). The β-TCP treated groups and SA-PRP group demonstrated higher OC percentage than DA-PRP and control groups (p<0.05).
CONCLUSION
The present findings suggest that DAPRP did not have a significant effect on the healing of non-critical size rabbit cranial bone defects.
目的
富血小板血浆(PRP)是一种将自体生长因子转移至伤口部位的新方法。本研究旨在通过检测骨粘连蛋白(ON)和骨钙素(OC)的表达,评估富血小板血浆二次应用(DA-PRP)对兔颅骨缺损骨愈合的疗效。
材料与方法
本研究纳入28只兔子,每只兔子均有两个通过手术制备的颅骨缺损,将其分为六组:缺损(N = 56)分别接受单次应用PRP(SA-PRP)(n = 10)、SA-PRP与β-磷酸三钙联合应用(SA-PRP +β-TCP)(n = 10)、仅DA-PRP(n = 8)、DA-PRP与β-磷酸三钙联合应用(DA-PRP +β-TCP)(n = 8)、仅β-磷酸三钙(β-TCP)(n = 10)或作为对照(n = 10)。术后第30天处死动物,对样本进行免疫组织化学检测以评估ON和OC的表达。
结果
结果表明,DA-PRP并未显著提高SA-PRP或对照组所达到的ON和OC百分比。三组接受β-TCP治疗的ON百分比高于未接受β-TCP治疗的组(p<0.05)。β-TCP治疗组和SA-PRP组的OC百分比高于DA-PRP组和对照组(p<?0.05)。
结论
本研究结果表明,DA-PRP对非临界尺寸兔颅骨缺损的愈合没有显著影响。